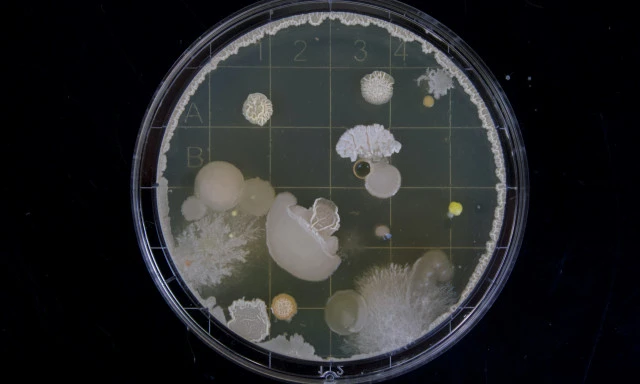

Solve problems in and around your home.
Start Problem Solver

A powerful anti-bacterial liquid spray that cleans surfaces, removes dirt, grease and grime.
*Independently tested to be effective against MHV-1 virus (Covid-19 [SARS-CoV-2] surrogate). See Test Report
^Post Consumer Waste HDPE Bottles are made from recycled milk bottles sourced from NZ curbside recycling and the labels are easy wash off to help with post use re-cycling.
Benzalkonium Chloride 0.5%, Pine Oil 0.25%.
Ready to Use: 650 ml, 1 L
SKU (650ml): H10210
SKU (1L): H10220
SORTED Multi-Purpose Surface Cleaner Ready to Use SDS
For full effectiveness against viruses mentioned leave for 2 minutes before wiping. For heavily soiled surfaces, follow 1-2-3 step directions above then repeat process leaving for 2 minutes before wiping off. Always test on an inconspicuous area for 5 minutes before use.
Bacteria are microscopic single celled organisms. Some can cause disease but most are beneficial or harmless.

Kill, remove and prevent black mould from exterior surfaces.

Viruses are the cause of many diseases. Virus particles can enter the cells of living organisms and where they u…